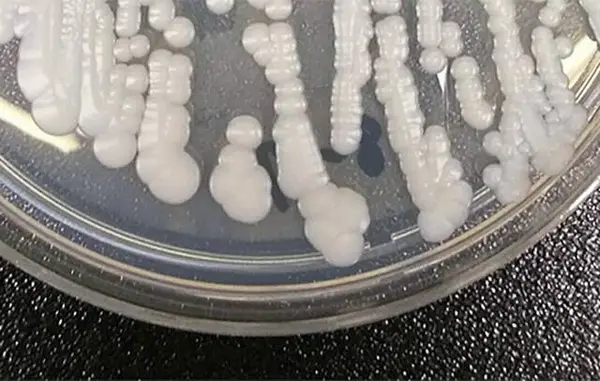

LOS ANGELES — A deadly, drug-resistant fungus that preys on the sick and old is continuing to spread in hospitals and senior care facilities across the country, killing more than 1 in 3 infected.
Candida auris, a type of yeast that can cause life-threatening illness, was first identified in the U.S. in 2016 with 52 infections reported across the country, according to the U.S. Centers for Disease Control and Prevention.
The number of cases has more than doubled annually, hitting 4,514 in 2023, the latest year the CDC has data available. During this same period, California reported 1,566 infections, more than any other state.
The CDC issued a public safety announcement declaring C. auris an “urgent threat” in 2023 because it is resistant to many antifungal drugs, spreads rapidly in health care facilities and can cause severe infections with high death rates.
“The rapid rise and geographic spread of cases is concerning and emphasizes the need for continued surveillance, expanded lab capacity, quicker diagnostic tests, and adherence to proven infection prevention and control,” CDC epidemiologist Dr. Meghan Lyman said.
Now, there are signs the fungus is again on the move. The Georgia Department of Public Health recently reported a surge in cases in health care facilities, and a recent study found an alarming rate of spread in Florida hospitals.
C. auris spreads through direct contact with colonized or infected individuals, contaminated surfaces and medical equipment.
The risk of infection is especially high for patients with catheters, breathing tubes or feeding tubes because they create direct entry points for C. auris to enter the bloodstream or lungs. Most healthy people are not at serious risk of complications from infections.
“Most of the patients that get infections with Candida auris are themselves pretty sick to start with,” said Stuart Cohen, chief of infectious diseases at UC Davis. “This is something that can push people over the edge and become life-threatening.”
Studies have found C. auris infections have a mortality rate of 30% to 60%.